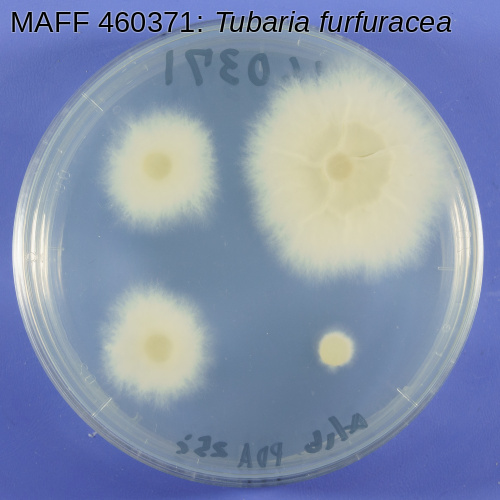

MAFF 460371の詳細
| MAFF番号 | 460371 |
| 微生物種類 | 糸状菌 |
| 学名 | Tubaria furfuracea (Persoon) Gillet |
| 同定者 | 岡部宏秋 |
| 分離源 | Tubaria furfuracea |
| 分離部位 | 子実体 |
| 採集地 | 茨城 (つくば市) |
| 採集日 | 1990/02 |
| 分離者 | 赤間慶子 |
| 提供者 | 赤間慶子 |
| 株名 | 617502 |
| 他機関保存 | 国立研究開発法人 森林総合研究所 FFPRI 460371 |
| 培地 | 麦芽寒天培地 (Malt Extract Agar (Difco)) |
| 培養適温 | 25℃ |
| 培養期間 | 30日 |
| 塩基配列 | ITS |
| 写真データ | |
| 配布申込 | 申込 |